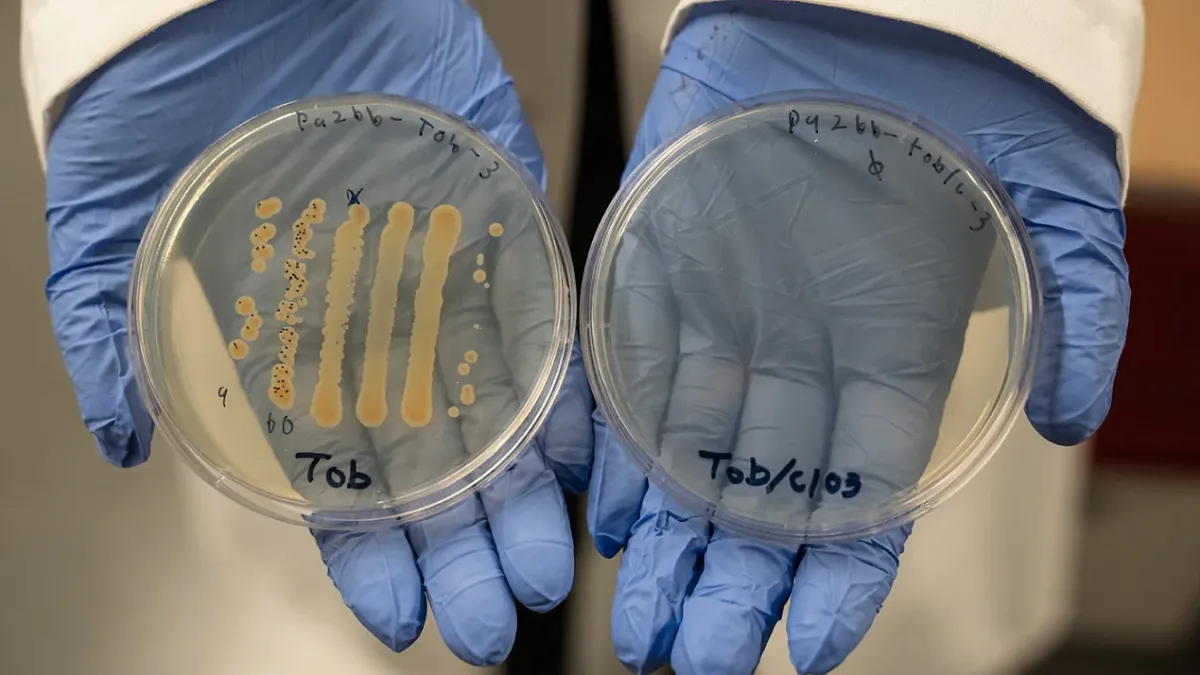

Soaring from the sidelines
Thanks to human physiology internships, these students are getting hands-on lessons in medicine and helping Ducks' sports soar.
By Nicole Krueger and Henry Houston
Experiential Learning | Research & Innovation | Community Impact | Career Preparation | Teaching Excellence | 21st Century Liberal Arts | Building Community | Good Vibes | CAS Spotlights | All Stories | Past Issues

All hail the King of Comics
Only one comics artist has influenced so much of our culture and it’s not the name people know best.
By Jenny Brooks
CAS gives antibiotics a boost
Researchers have tested a new combination drug therapy that could dismantle difficult-to-treat bacteria.
By Leila Okahata

NASA team ignites curiosity at UO
The next generation of scientists joined a meeting with professionals guiding a NASA spacecraft.
By Henry Houston

How race shapes everyday life
A new book by Professor Jessica Vasquez-Tokos uncovers how race influences personal experiences.
By Henry Houston

Computer science alum weaves together ambition and generosity to kickstart his career
When Fedi Aniefuna arrived at the UO, he still hadn’t decided whether he wanted to major in political science and go to law school, or study computer science and head straight into the workforce. Five years later, he’s beginning his second year as an engineer with Amazon Web Services after choosing math and computer science.
Where athletes maximize performance
“When we first had the vision for this lab, it was not only understanding mechanisms that might be limiting human performance, but we also really wanted to translate that out into the community,” said Professor Brad Wilkins, founder and director of the Oregon Performance Research Lab. “Our community testing services program is really taking the research and translating that to people in the community that really want to improve their performance.”
The lab offers a number of testing services to athletes in the community, including threshold testing, VO2 max, hemoglobin mass and sweat testing.
Find CAS on Instagram
Connect with Us
CAS Connection is produced by the CAS Communications Department.
Got something to say? Send us your story ideas or contact us at CASConnection@uoregon.edu.
We know you don’t want to miss a single moment of CAS greatness. Stay plugged into the #CASCommunity by following us on your favorite channels.
|
|
|
|
|






